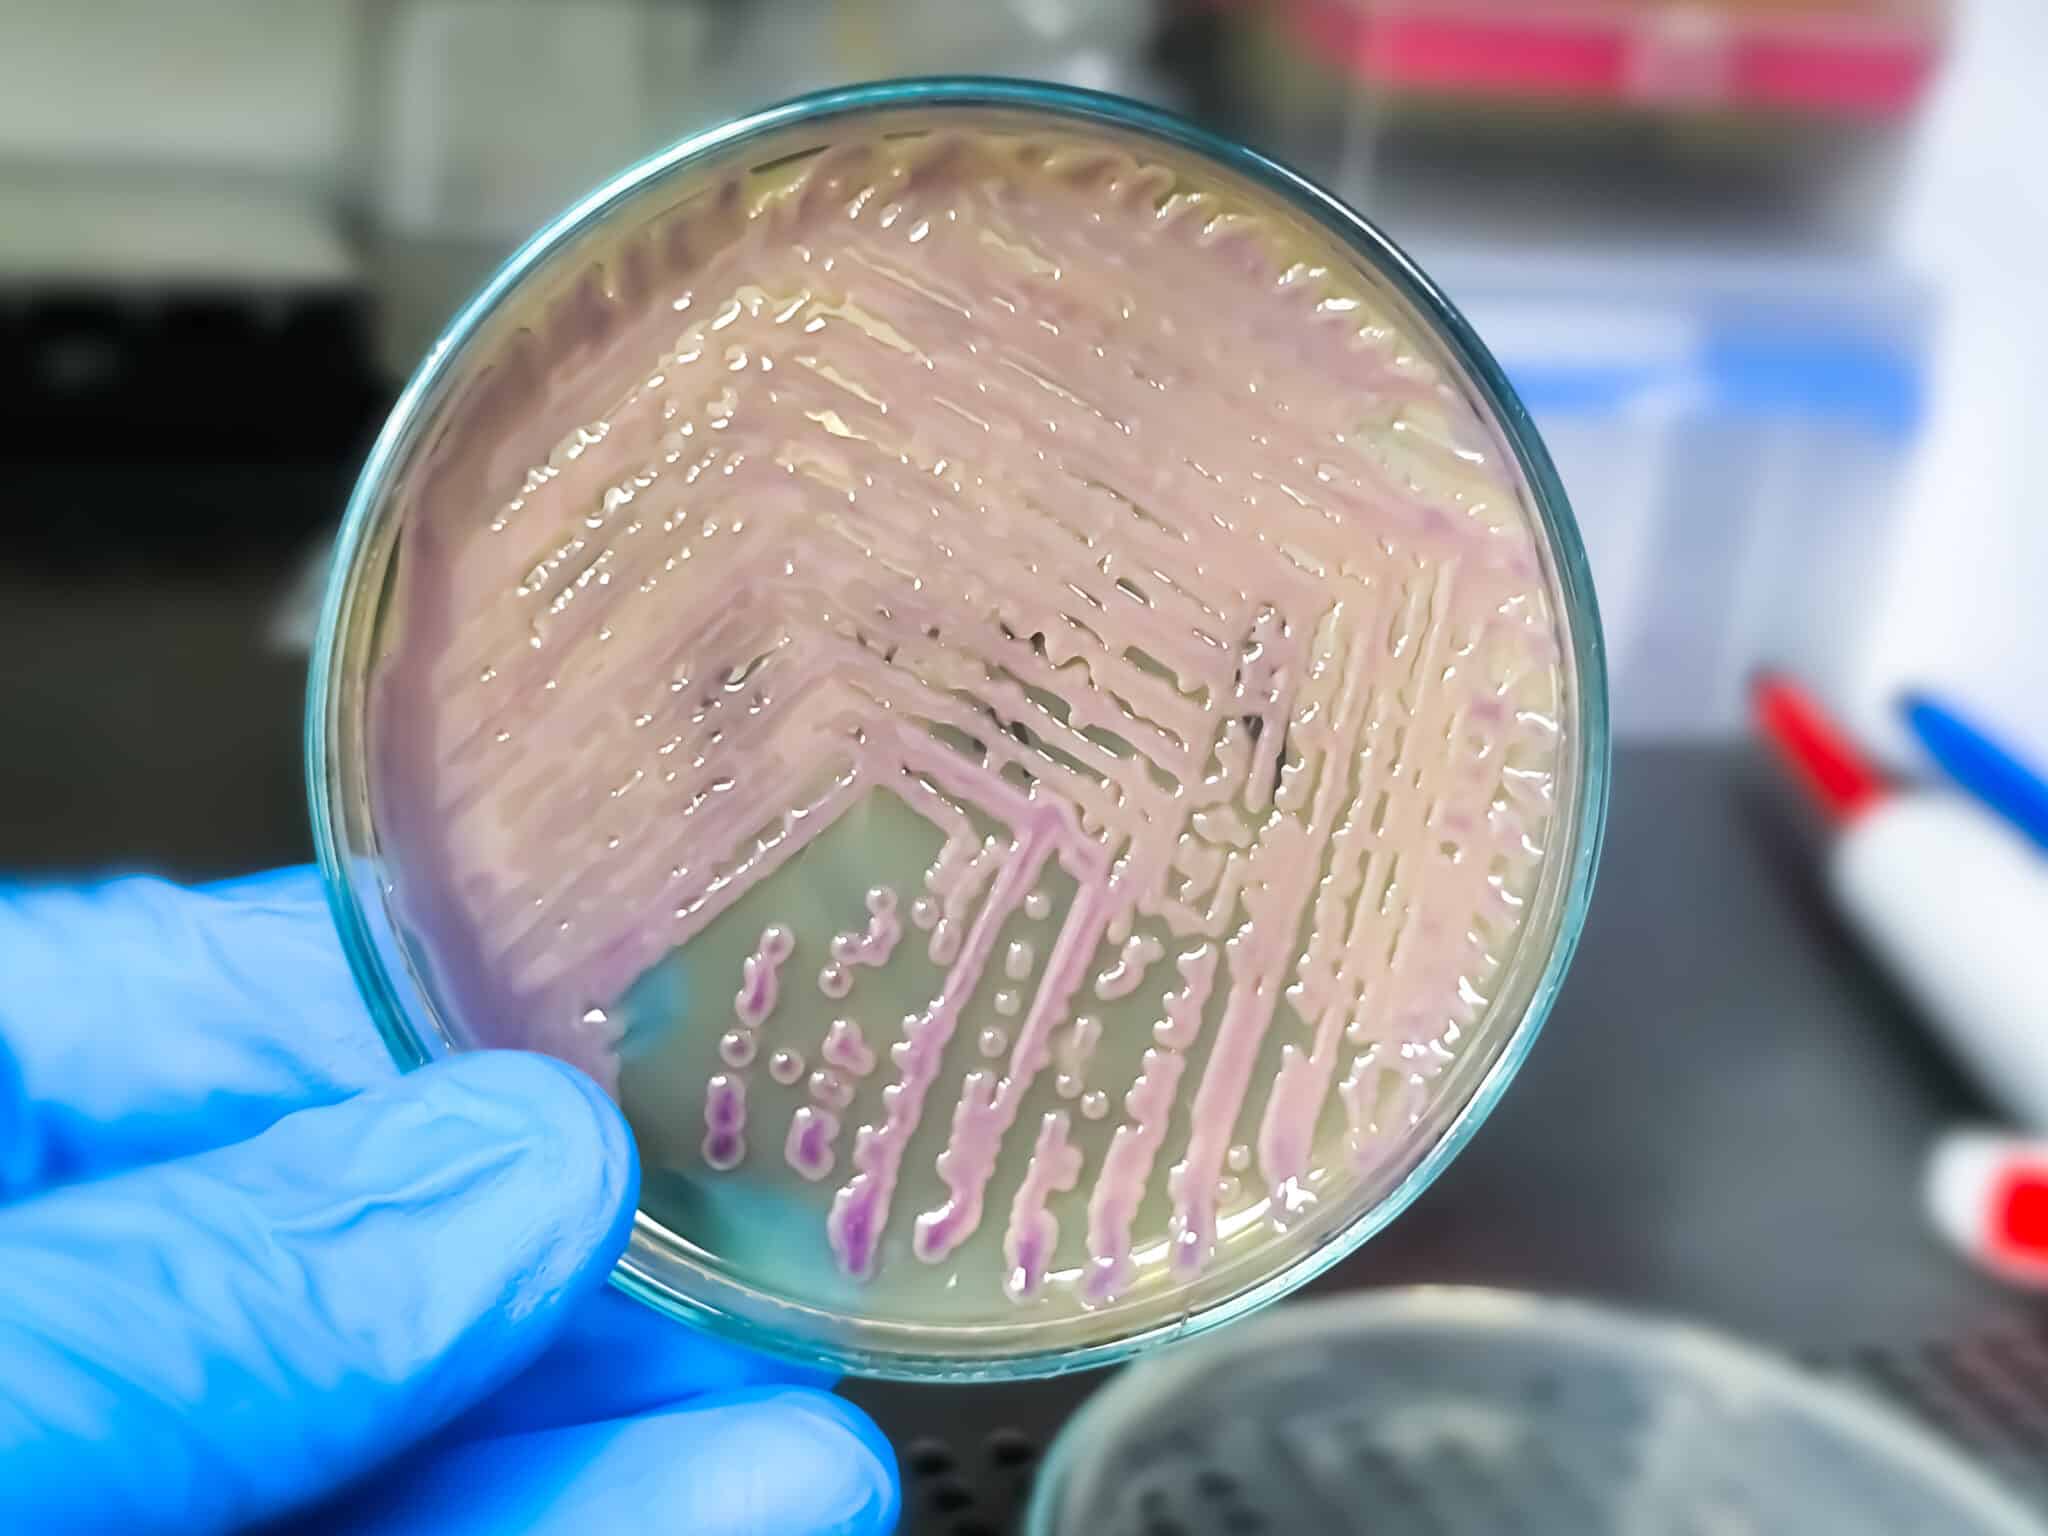
Scientist holding petri dish with colony of Escherichia coli (E. coli)

(© Pamela Au - stock.adobe.com)
3 key factors create ‘perfect storm’ for colorectal cancer development
In a nutshell
- A low-carb diet lacking fiber can thin gut mucus barriers and increase inflammation, creating an environment where cancer-causing bacteria thrive
- People with DNA repair deficiencies (like Lynch syndrome) face particularly high risk when combining low-fiber diets with certain gut bacteria
- Adding soluble fiber like inulin to low-carb diets significantly reduced cancer risk in the study, suggesting a simple protective measure
TORONTO — If you’ve been thinking about switching to a low-carb diet, you might want to reconsider. Recent research has uncovered a concerning link between low-fiber diets, certain gut bacteria, and colorectal cancer. Scientists from the University of Toronto discovered that when these factors combine with specific genetic conditions, they create what researchers call a “perfect storm” for cancer development.
Colorectal cancer kills roughly a million people worldwide each year, making it the third deadliest cancer. While we’ve known that diet, gut bacteria, inflammation, and genetics all contribute to this disease, we haven’t fully understood how these factors work together. This new research helps connect these dots.
“Our question was, does diet influence the ability of specific bacteria to cause cancer?” says senior author Alberto Martin, a professor of immunology at U of T’s Temerty Faculty of Medicine, in a statement.
The team, led by Martin and postdoctoral fellow Bhupesh Thakur, found that a diet low in carbohydrates and fiber dramatically increases cancer risk when combined with certain E. coli bacteria. Not just any E. coli, but specifically strains that make a toxin called colibactin, which damages DNA. These bacteria are found in about 60% of colorectal cancer cases.
“Colorectal cancer has always been thought of as being caused by a number of different factors including diet, gut microbiome, environment and genetics,”
The popularity of low-carb diets makes these results particularly relevant. While these diets may help with weight loss, they could have unexpected consequences if they lack adequate fiber.

Diet, Bacteria, and Cancer
To answer Martin’s question, the researchers examined mice that were colonized with one of three bacterial species previously linked to colorectal cancer and fed either a normal, low-carb, or Western-style diet.
The results were clear. Only one combination — a low-carb diet paired with a strain of E. coli that produces colibactin — led to the development of colorectal cancer. Mice on the low-carb diet developed more colon polyps (abnormal growths that can become cancerous) than those on other diets. When these same mice were infected with colibactin-producing E. coli, polyp numbers jumped even higher, and many showed signs of turning cancerous.
Surprisingly, the Western-style diet didn’t cause the same cancer-promoting effects, despite its bad reputation. The key factor appeared to be low fiber content, rather than high fat or sugar.
The researchers tested three different bacteria linked to colorectal cancer: Bacteroides fragilis, Helicobacter hepaticus, and the E. coli strain NC101. Only the E. coli strain, when combined with the low-carb diet, significantly increased polyp formation.
The danger of this E. coli lies in its ability to produce colibactin, which directly damages DNA. When the researchers used a mutant version of the E. coli that couldn’t make colibactin, the cancer-promoting effects vanished, even on the low-carb diet.
About 20% of healthy people, 40% of inflammatory bowel disease patients, and 60% of colorectal cancer patients carry these potentially harmful bacteria without knowing it.
Why Low-Fiber Diets Create Problems
The research identified several ways a low-fiber diet creates favorable conditions for cancer:
First, the researchers found that a diet deficient in fiber increased inflammation in the gut and altered the community of microbes that typically reside there, creating an environment that allowed the colibactin-producing E. coli to thrive.
Second, they also showed that mice fed a low-carb diet had a thinner layer of mucus separating the gut microbes from the colon epithelial cells. “The mucus layer acts as a protective shield between the bacteria in the gut and the cells underneath. With a weakened barrier, more colibactin could reach the colon cells to cause genetic damage and drive tumor growth,” the researchers explained.
Third, inflammation from the low-fiber diet increased nitric oxide production, creating higher nitrate levels in the gut. This gave E. coli bacteria a growth advantage, letting them thrive and cause more damage.
The researchers confirmed this mechanism by treating some mice with a nitric oxide inhibitor, which reduced both E. coli growth and tumor formation, even on the low-fiber diet.
Human Evidence
To check if their findings might apply to humans, the researchers analyzed data from two human studies.
In the DIETFITS study, people on a low-carb diet showed higher levels of intestinal inflammation markers and increased E. coli after three months. In the GEM cohort, fiber intake was negatively linked with inflammation markers, while inflammation markers were positively linked with E. coli levels.
While both Thakur and Martin emphasize the need to confirm these findings in humans, the initial human data support what they saw in mice, indicating similar mechanisms might be at work in people.

Fiber Supplements to the Rescue
In one of the most promising aspects of the study, adding inulin (a type of soluble fiber) to the low-carb diet reversed many of the cancer-promoting effects in mice.
“We supplemented fiber and saw that it reduced the effects of the low-carb diet,” Thakur says. “Now we are trying to find out which fiber sources are more beneficial, and which are less beneficial.”
Mice given inulin had fewer polyps, less inflammation, and fewer DNA-damaging bacteria, even while still eating the low-carb diet. Fiber supplements may offer a way to reduce risks associated with low-carb diets.
“Our study highlights the potential dangers associated with long-term use of a low-carb, low-fiber diet, which is a common weight-reducing diet,” says Martin. “More work is needed but we hope that it at least raises awareness.”
Low-carb diets aren’t necessarily bad for everyone. The researchers recommend people on such diets consider fiber supplements or ensure they eat enough fiber-rich foods that fit their diet plan.
The Genetic Component
The story doesn’t end with diet and bacteria. The researchers also discovered that certain genetic mutations made mice even more susceptible to the cancer-promoting effects of colibactin-producing E. coli.
Specifically, mice with defects in a DNA repair system called mismatch repair (MMR) developed significantly more polyps when infected with the colibactin-producing bacteria. This is particularly relevant to human colorectal cancer, as approximately 15% of cases involve defects in this same repair system.
The researchers found that in mice with MMR deficiency, the colibactin toxin induced a state called senescence in colon cells. Senescent cells stop dividing but remain metabolically active, secreting inflammatory factors that can promote cancer—a phenomenon known as the senescence-associated secretory phenotype (SASP).
When the researchers treated these mice with a compound called fisetin, which selectively kills senescent cells, the number of polyps decreased. This suggests that targeting senescent cells might be a way to reduce cancer risk in individuals with MMR deficiency.
Those with MMR deficiency or inflammatory conditions may face higher risks from a low-fiber diet combined with certain gut bacteria.
The Three-Factor Model
Pulling everything together, the researchers propose a three-factor model for colorectal cancer development:
- A low-fiber diet creates inflammation and reduces the protective mucus layer in the colon.
- Colibactin-producing E. coli bacteria thrive in this environment and damage the DNA of colon cells.
- Genetic defects in DNA repair make cells more vulnerable to this damage and more likely to become cancerous.
Any one factor alone might not cause cancer, but together they create dangerous synergy that substantially increases risk.
Looking Forward
The researchers suggest several ways to reduce colorectal cancer risk based on their findings:
- Ensuring adequate fiber intake through diet or supplements
- Targeted screening for high-risk individuals, especially those with Lynch syndrome
- Potential antibiotic treatments for people with both high genetic risk and colibactin-producing bacteria
- Personalized approaches to diet and probiotic use based on genetic background
By maintaining a healthy balance between what we eat and the microbes living in our gut, we might keep cancer at bay and live healthier lives. This research highlights how something as simple as adding more fiber to a low-carb diet could potentially make a significant difference in cancer prevention for high-risk individuals.
Paper Summary
Methodology
The researchers used various mouse models to see how diet, gut bacteria, and genetics interact to promote colorectal cancer. They tested three diets (normal, low-carb, and Western-style) and three bacteria linked to colorectal cancer. They monitored the mice for colon polyp development and analyzed tissues for inflammation, DNA damage, and bacterial growth. They also tried various treatments including fiber supplements, an anti-inflammatory drug, a nitric oxide inhibitor, and a compound that kills senescent cells. To check relevance to humans, they looked at data from two human studies examining inflammation markers, fiber intake, and E. coli levels.
Results
The study found that mice on low-carb diets developed more colon polyps than those on other diets, especially when also infected with colibactin-producing E. coli. This combination thinned the protective mucus layer, increased inflammation, and caused more DNA damage in colon cells. The low-carb diet specifically increased nitric oxide production, creating an environment where E. coli could thrive. Mice with DNA repair defects were particularly vulnerable to the cancer-promoting effects of these bacteria, showing signs of cellular senescence. Adding fiber or using drugs that target inflammation or senescent cells reduced polyp formation. Human data supported these findings, showing connections between low fiber intake, inflammation, and E. coli levels.
Limitations
While the mouse models provide useful insights, they don’t perfectly mirror human cancer development. The study focused on specific bacteria and genetic mutations, but human colorectal cancer involves many more factors. The human data, while supportive, were observational and can’t prove cause and effect. Both Thakur and Martin emphasize the need to confirm these findings in humans before making definitive dietary recommendations. The researchers note that diet and bacteria effects might vary depending on genetic background, gut microbiome composition, and environmental factors.
Discussion and Takeaways
The researchers propose that diet, microbiome, and genetics create a “perfect storm” for colorectal cancer. A low-fiber diet creates gut inflammation, promotes growth of DNA-damaging bacteria, and allows them to contact colon cells directly. DNA damage is particularly harmful in people with repair defects like MMR. The study highlights fiber’s importance not just for its mechanical properties but for supporting beneficial bacteria and reducing inflammation. For prevention, they suggest adequate fiber intake, screening high-risk individuals, and personalizing diet and probiotic approaches based on genetics and microbiome. Targeting inflammation or senescent cells might help prevent or treat colorectal cancer, especially in high-risk individuals.
Funding and Disclosures
This research was funded by the Canadian Institutes of Health Research. The authors declared no competing interests. The GEM cohort work was approved by the Mount Sinai Hospital Research Ethics Board and local recruitment centers. Use of human stool samples from the DIETFITS study was approved by the University of Toronto Health Sciences Research Ethics Board.
Paper Details
The paper “Dietary fibre counters the oncogenic potential of colibactin-producing Escherichia coli in colorectal cancer” was published in Nature Microbiology on March 3, 2025 (DOI: 10.1038/s41564-025-01938-4). The research was conducted by a team from the University of Toronto led by Alberto Martin and postdoctoral fellow Bhupesh Thakur.








What big pharma or food company sponsored this research? Or which big pharma or food company is one of the biggest contributors to this university? People really need to do their own background research when reading articles like this as it has recently come to the light of day the past few years how many of these research trials/papers are purposely flawed but made to look like absolute truth and produced by researchers and universities secretly or outright funded or significantly supported by big pharma or food companies.